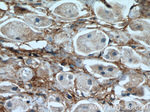
Fibronectin Antibody in Immunohistochemistry (Paraffin) (IHC (P))

Search
Proteintech
Fibronectin Monoclonal Antibody (1G10F9)
{{$productOrderCtrl.translations['antibody.pdp.commerceCard.promotion.promotions']}}
{{$productOrderCtrl.translations['antibody.pdp.commerceCard.promotion.viewpromo']}}
{{$productOrderCtrl.translations['antibody.pdp.commerceCard.promotion.promocode']}}: {{promo.promoCode}} {{promo.promoTitle}} {{promo.promoDescription}}. {{$productOrderCtrl.translations['antibody.pdp.commerceCard.promotion.learnmore']}}

Please note: We are reviewing Western blot images included in the antibody testing data in our catalog, including those provided by third parties. Unless expressly labeled or annotated as “raw-unedited”, Western blot images included in the antibody testing data in our catalog may have been edited, optimized or otherwise adjusted for presentation.
产品信息
66042-1-IG
种属反应
已发表种属
宿主/亚型
分类
类型
克隆号
抗原
偶联物
形式
浓度
规格
纯化类型
保存液
内含物
保存条件
运输条件
产品详细信息
Immunogen sequence: DQQRHKVRE EVVTVGNSVN EGLNQPTDDS CFDPYTVSHY AVGDEWERMS ESGFKLLCQC LGFGSGHFRC DSSRWCHDNG VNYKIGEKWD RQGENGQMMS CTCLGNGKGE FKCDPHEATC YDDGKTYHVG EQWQKEYLGA ICSCTCFGGQ RGWRCDNCRR PGGEPSPEGT TGQSYNQYSQ RYHQRTNTNV NCPIECFMPL DVQADREDSR E (2177-2386 aa encoded by BC005858)
靶标信息
Fibronectin is a disulfide-bonded dimer with a molecular weight range of 230-250 kDa. In the extracellular matrix of several connective tissues and vessels, fibronectin is present as an insoluble protein that is extensively cross-linked by interchain disulfide bonds forming high molecular mass polymers. Fibronectin is most abundant during embryonic development and tissue remodeling. Fibronectin is also present at high concentrations as a soluble plasma protein. Fibronectin is organized as a linear series of repeating modules which form domains for interaction with fibronectin itself, other matrix components (e.g. collagen and heparin) and receptors on cells (e.g. integrins). Fibronectin is present in a soluble dimeric form in plasma, and in a dimeric or multimeric form at the cell surface and in extracellular matrix. Fibronectin is involved in cell adhesion and migration processes including embryogenesis, wound healing, blood coagulation, host defense, and metastasis. Fibronectin has been implicated in carcinoma development in lung cancer. Further, Fibronectin expression is increased especially in non-small cell lung carcinoma. The adhesion of lung carcinoma cells to Fibronectin enhances tumorgenecity and confers resistance to apoptosis induced by standard chemotherapeutic agents. The gene encoding Fibronectin has three regions subject to alternative splicing, with the potential to produce 20 different transcript variants. However, the full-length nature of some Fibronectin variants has not been determined.
仅用于科研。不用于诊断过程。未经明确授权不得转售。
生物信息学
蛋白别名: CIG; Cold insoluble globulin (CIG); Cold-insoluble globulin; DKFZp686F10164; DKFZp686H0342; DKFZp686I1370; DKFZp686O13149; ferritin L subunit; ferritin L-chain; Fibronectin; FN; Migration stimulating factor (MSF)
基因别名: E330027I09; FIBNEC; FN; Fn-1; FN1
UniProt ID: (Mouse) P11276
Entrez Gene ID: (Mouse) 14268, (Rat) 25661




